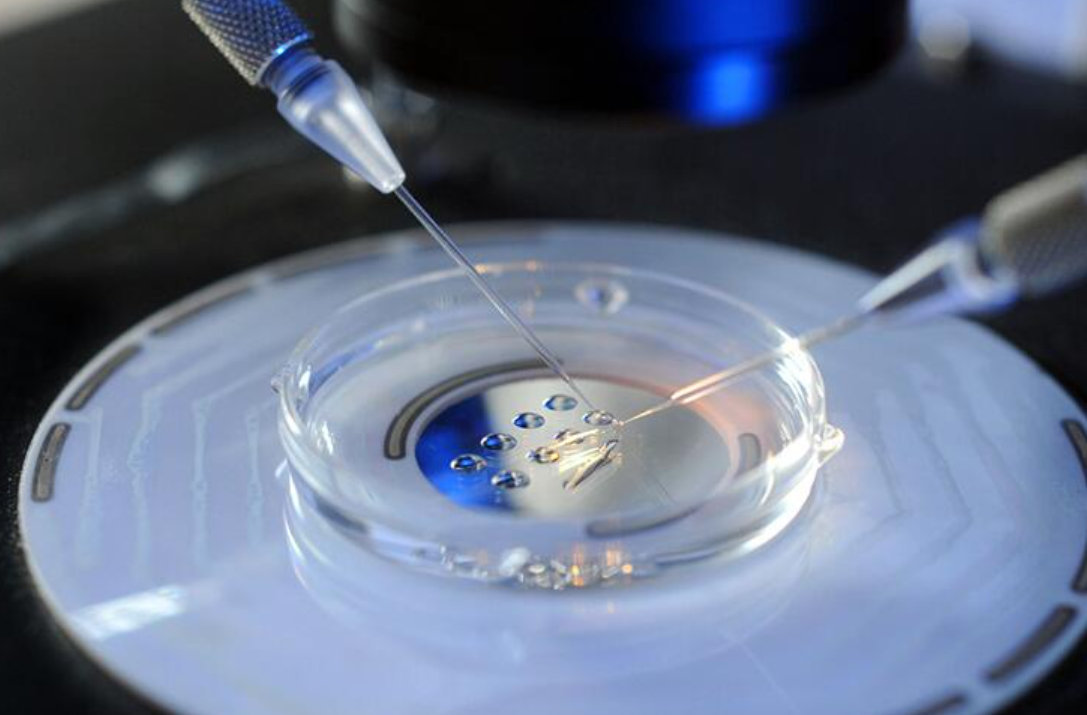

试管囊肿穿刺的意义和作用,影响试管成功率只是其中之一,在试管疗程中,如果女性有肿囊,那么是不利于做试管的,因此在开展试管疗程之前,是需要做穿刺手术的,但由于每位患者的情况不同,因此有些患者是不需要做这一手术的,因此具体情况还得看患者的病症严重程度。
试管囊肿穿刺必要吗
试管囊肿穿刺手术要根据具体情况判断是否要做,如果囊肿相对较小,也属于良性的话,那么是可以做试管的,但如果囊肿会影响整个试管过程,则需要景象穿刺手术过后再做试管,所以对于一些女性来说,如果囊肿会影响到卵泡的发育和移植则需要做手术。
因此,女性试管囊肿穿刺手术应根据医生的具体判断来进行。在做试管之前,医生会安排大量的检查,只有做好这些检查,医生才能判断女性的身体是否能做试管的条件。而是否需要做这些手术,也可根据以下情况进行判断,具体如下:
1、首先,需要在专业的医院判断囊肿的性质,确定囊肿是良性还是恶性的。良性囊肿一般可以不予治疗或者通过保守的药物与饮食治疗即可;
2、囊肿较大时,应考虑穿刺治疗,但囊肿必须良性的。如果是巧囊,那么穿刺可能会引起其他部位的感染;
3、如果囊肿是恶性的,建议患者先治疗,然后可以选择切除病灶的治疗方法。
囊肿影响试管成功率吗
女性囊肿是否会影响试管的成功率取决于囊肿的大小和良性恶性来判断。如果良性囊肿偏小,且在医生的判断下不会影响试管的成功率,那么是可以做试管的。但如果是恶性肿瘤,那么穿刺后需要做试管,否则可能会影响整个试管的疗程。
女性试管前进行囊肿穿刺数,一般需要等待三个月至半年后,才能做试管,此时最好调节身体观察做好审查工作才不会影响后期试管的成功率,而太早做试管,卵巢尚未完全恢复,是不利于排卵或后期移植的。
由此可见,试管肿囊穿刺主要为了提高试管的成功率,否则不仅会影响到女性的身体健康,同时还会降低做试管的成功率,这里建议患者在出现这一疾病后,一定要及时治疗,以免危害到身体的健康。







